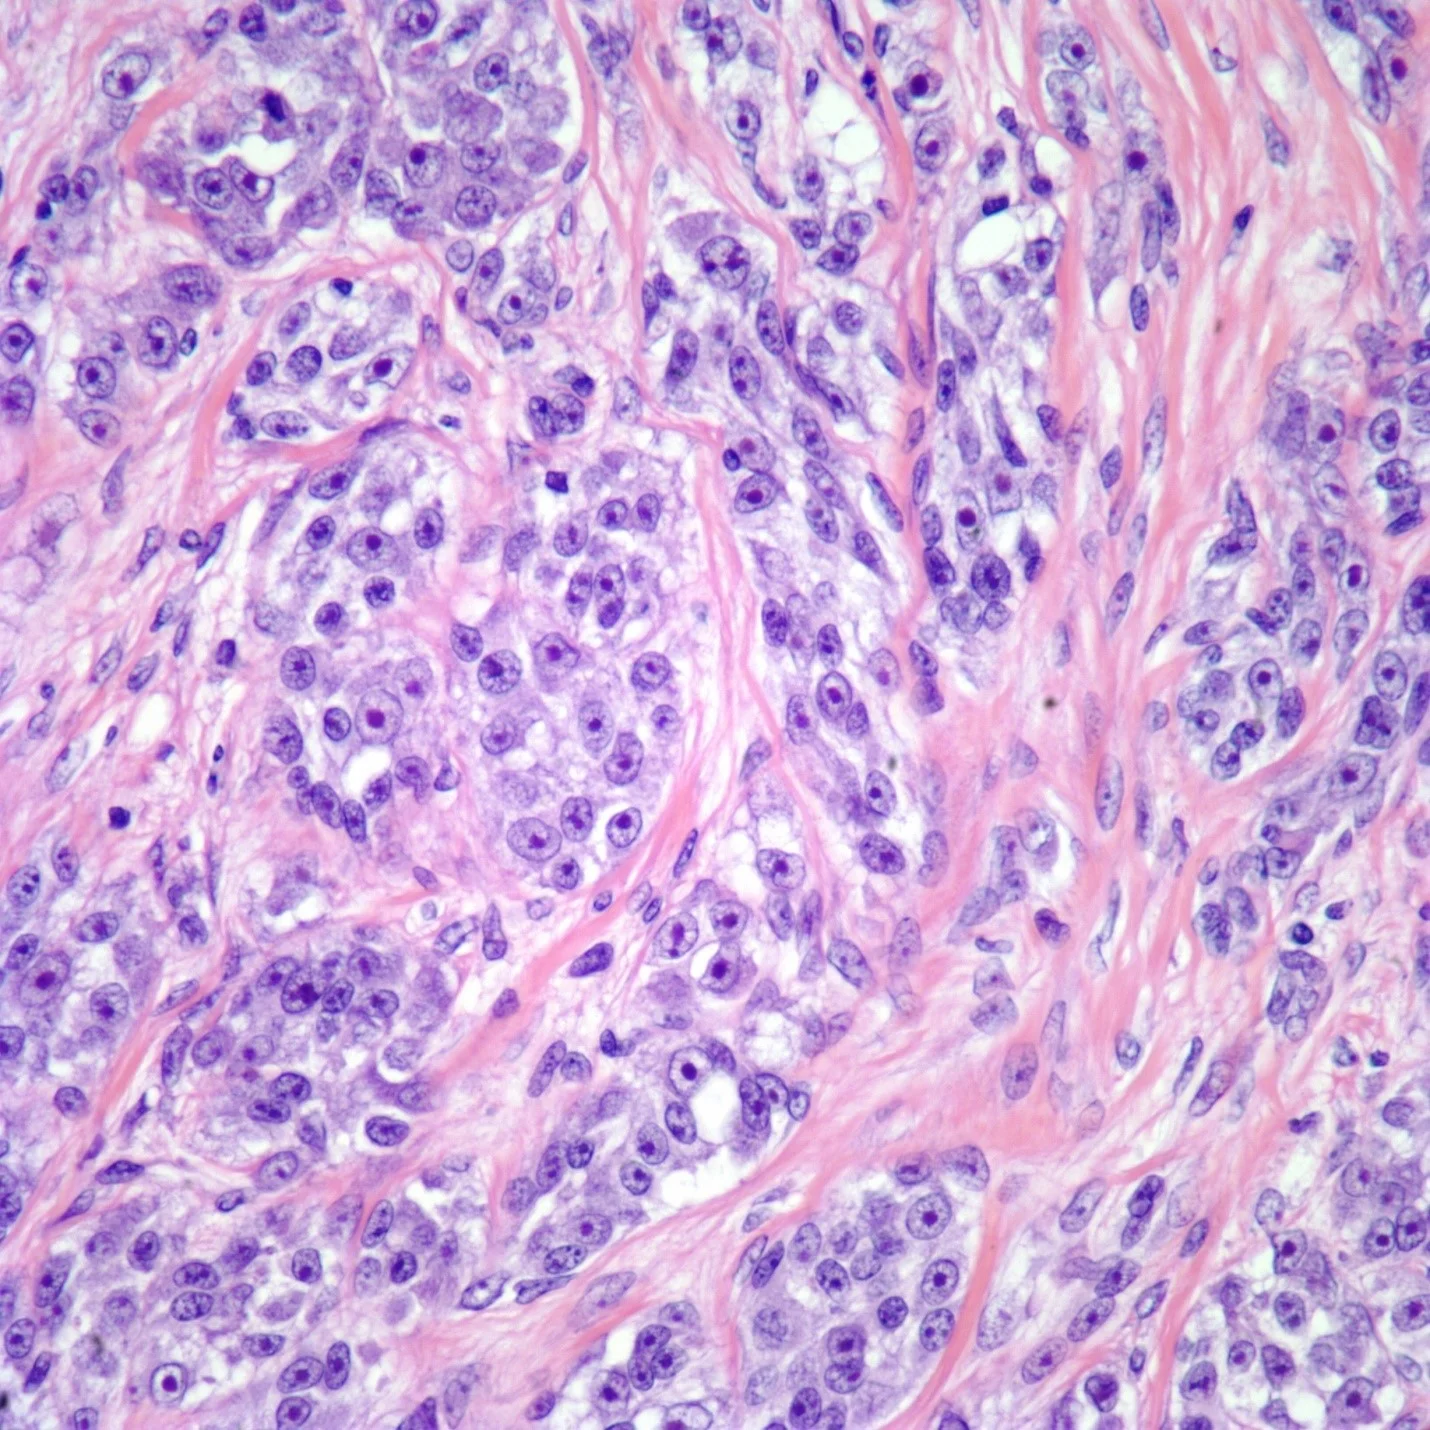
رنگ آمیزی سارکوم بافت نرم

مقدمهای بر سارکوم بافت نرم (Soft Tissue Sarcoma)
سرطان زمانی شروع میشود که سلولها شروع به رشد خارج از کنترل کنند. سلولها تقریباً در هر قسمت از بدن میتوانند به سرطان تبدیل شوند و به نواحی دیگر گسترش یابند.
انواع مختلفی از تومورهای بافت نرم وجود دارد و همه آنها سرطانی نیستند. بسیاری از تومورهای خوش خیم در بافتهای نرم یافت میشوند. کلمه خوش خیم به این معنی است که آنها سرطانی نیستند. این تومورها نمیتوانند به سایر قسمتهای بدن گسترش یابند. برخی از تومورهای بافت نرم به روشی بین حالات سرطانی و غیر سرطانی رفتار میکنند. به اینها تومورهای بافت نرم میانی (intermediate soft tissue tumors) گفته میشود.
هنگامی که کلمه سارکوم بخشی از نام یک بیماری است، به این معنی است که تومور بدخیم (سرطان) است. سارکوم نوعی سرطان است که در بافتهایی مانند استخوان یا ماهیچه شروع میشود.
سارکومهای استخوان و بافت نرم انواع اصلی سارکوم هستند. سارکوم بافت نرم میتواند در بافتهای نرمی مانند چربی، ماهیچه، اعصاب، بافتهای فیبری، رگهای خونی یا بافتهای عمیق پوست ایجاد شود. آنها را میتوان در هر قسمت از بدن یافت. بیشتر آنها از بازوها یا پاها شروع میشوند. آنها همچنین میتوانند در تنه، ناحیه سر و گردن، اندامهای داخلی و ناحیه پشت حفره شکمی (شکم) (معروف به retroperitoneum) یافت شوند. سارکوم بیماری شایعی نیست.
سارکومهایی که اغلب از استخوانها شروع میشوند، مانند استئوسارکوم (osteosarcomas) و سارکومهایی که اغلب در کودکان دیده میشوند، مانند تومورهای خانواده یوینگ (Ewing family of tumors) و رابدومیوسارکوم (rhabdomyosarcomas)، در اینجا پوشش داده نمیشوند و در مطالب جداگانه ای به طور کامل توضیح داده شده اند.
انواع سارکوم بافت نرم
بیش از 50 نوع مختلف سارکوم بافت نرم وجود دارد. برخی از آنها بسیار نادر هستند و همه در اینجا ذکر نشده اند:
- فیبروسارکوم بزرگسالان (Adult fibrosarcoma) معمولاً بافت فیبری را در پاها، بازوها یا تنه تحت تأثیر قرار میدهد. این بیماری بیشتر در افراد بین 20 تا 60 سال شایع است اما میتواند در افراد در هر سنی و حتی در نوزادان نیز رخ دهد.
- سارکوم قسمت نرم آلوئولار (Alveolar soft-part sarcoma) سرطان نادری است که بیشتر بزرگسالان جوان را مبتلا میکند. این تومورها اغلب از پاها شروع میشوند.

- آنژیوسارکوم (Angiosarcoma) میتواند در عروق خونی (همانژیوسارکوم یا hemangiosarcomas) یا در عروق لنفاوی (لنفانژیوسارکوم یا lymphangiosarcomas) شروع شود. این تومورها گاهی در قسمتی از بدن که تحت درمان با اشعه قرار گرفته است، شروع میشوند. گاهی اوقات آنژیوسارکوم در پستان پس از پرتو درمانی و در اندامهای مبتلا به ادم لنفاوی دیده میشود.
- سارکوم سلول شفاف (Clear cell sarcoma) یک سرطان نادر است که اغلب از تاندونهای بازو یا پا شروع میشود. در زیر میکروسکوپ، برخی از ویژگیهای ملانوم بدخیم – نوعی سرطان که در سلولهای پوستی تولید کننده رنگدانه شروع میشود – را دارد. اینکه چگونه سرطانهایی با این ویژگیها در قسمتهایی از بدن به غیر از پوست شروع میشود، مشخص نیست.
- تومور سلول گرد کوچک دسموپلاستیک (Desmoplastic small round cell tumor) یک سارکوم نادر در نوجوانان و جوانان است. اغلب در شکم (belly) یافت میشود.

- سارکوم اپیتلیوئیدی (Epithelioid sarcoma) اغلب در بافتهای زیر پوست دست، ساعد، پا یا ساق پا شروع میشود. نوجوانان و جوانان اغلب تحت تأثیر قرار میگیرند.
- سارکوم فیبرومیکسوئید (Fibromyxoid sarcoma) با درجه پایین سرطانی با رشد آهسته است که اغلب به صورت توده بدون درد در تنه یا بازوها و پاها (به ویژه ران) شروع میشود. در افراد جوان تا میانسال شایع تر است. گاهی اوقات تومور ایوانز (Evans’ tumor) نامیده میشود.

- تومور استرومایی گوارشی (Gastrointestinal stromal tumor یا GIST) نوعی سارکوم است که از دستگاه گوارش شروع میشود. برای جزئیات بیشتر به مطلب تومور استرومایی گوارشی (GIST) مراجعه کنید.
- سارکوم کاپوسی (Kaposi sarcoma) نوعی سارکوم است که در سلولهای پوششی لنف یا رگهای خونی شروع میشود. مطلب سارکوم کاپوسی را مطالعه کنید.

- لیومیوسارکوم (Leiomyosarcoma) نوعی سرطان است که از بافت ماهیچه صاف شروع میشود. این تومورها اغلب از شکم شروع میشوند اما میتوانند در سایر قسمتهای بدن مانند بازوها یا پاها یا رحم نیز شروع شوند (به مطلب سارکوم رحم مراجعه کنید).

- لیپوسارکومها (Liposarcomas) تومورهای بدخیم بافت چربی هستند. آنها میتوانند از هر جایی از بدن شروع شوند اما اغلب از ران، پشت زانو و داخل پشت شکم شروع میشوند. آنها بیشتر در بزرگسالان بین 50 تا 65 سال رخ میدهند.

- مزانشیموما بدخیم (Malignant mesenchymoma) نوع نادری از سارکوم است که ویژگیهای فیبروسارکوم و ویژگیهای حداقل 2 نوع سارکوم دیگر را نشان میدهد.
- تومورهای بدخیم غلاف عصبی محیطی (Malignant peripheral nerve sheath tumors) شامل نوروفیبروسارکوم (neurofibrosarcomas)، شوانوم بدخیم (malignant schwannomas) و سارکوم نوروژنیک (neurogenic sarcomas) است. این سارکومها در سلولهایی که عصب را احاطه کرده اند، شروع میشوند.

- میکسوفیبروسارکوم (Myxofibrosarcomas) با درجه پایین اغلب در بازوها و پاهای افراد مسن دیده میشود. آنها بیشتر در داخل یا فقط زیر پوست هستند و ممکن است بیش از یک تومور در افراد مبتلا وجود داشته باشد.
- رابدومیوسارکوم (Rhabdomyosarcoma) شایع ترین نوع سارکوم بافت نرم در کودکان است.
- سارکوم سینوویال (Synovial sarcoma) تومور بدخیم بافت اطراف مفاصل است. شایع ترین مکانها عبارتند از: ران، زانو، مچ پا و شانه. این تومور در کودکان و بزرگسالان جوان شایع تر است اما ممکن است در افراد مسن نیز رخ دهد.

- سارکوم پلئومورفیک تمایز نیافته (UPS یا Undifferentiated pleomorphic sarcoma) زمانی هیستیوسیتوم فیبری بدخیم (MFH یا malignant fibrous histiocytoma) نامیده میشد. این نوع اغلب در بازوها یا پاها دیده میشود. در موارد کمتر رایج، میتواند از داخل در پشت شکم (صفاق خلفی یا retroperitoneum) شروع شود. این سارکوم بیشتر در افراد مسن دیده میشود. بیشتر تمایل دارد به بافتهای دیگر اطراف جایی که شروع شده رشد کند اما میتواند به نقاط دورتر بدن گسترش یابد.
تومورهای میانی بافت نرم (Intermediate soft tissue tumors)
این تومورها ممکن است رشد کرده و به بافتها و اندامهای مجاور حمله کنند اما تمایل ندارند به سایر قسمتهای بدن گسترش پیدا کنند.
- Dermatofibrosarcoma protuberans یک تومور با رشد آهسته بافت فیبری زیر پوست، معمولاً در تنه یا اندامها است. در بافتهای مجاور رشد میکند اما به ندرت به مکانهای دور گسترش مییابد.
- فیبروماتوز (Fibromatosis) نامی است که به تومورهای بافت فیبری با ویژگیهای بین فیبروسارکوم و تومورهای خوش خیم مانند فیبروم داده میشود (به مباحث زیر مراجعه کنید). آنها به آرامی اما اغلب به طور پیوسته رشد میکنند. آنها همچنین تومورهای دسموئید (desmoid tumors) و همچنین با نام علمی تر فیبروماتوز عضلانی آپونورتیک (musculoaponeurotic fibromatosis) یا فقط فیبروماتوز تهاجمی (aggressive fibromatosis) نامیده میشوند. آنها به ندرت و یا هرگز، به نقاط دورتر بدن گسترش مییابند اما میتوانند با رشد در بافتهای مجاور مشکلاتی ایجاد کنند. آنها گاهی اوقات حتی میتوانند کشنده باشند. برخی از پزشکان آنها را نوعی فیبروسارکوم با درجه پایین میدانند اما برخی دیگر معتقدند که آنها یک نوع منحصر به فرد تومور بافت فیبری هستند. برخی هورمونها مانند استروژن باعث رشد برخی از تومورهای دسموئید میشوند. داروهای ضد استروژن گاهی اوقات برای درمان دسموئید مفید هستند که نمیتوان آنها را بهطور کامل با جراحی از بین برد.
- Hemangioendothelioma یک تومور رگ خونی است که به عنوان سرطان با درجه پایین در نظر گرفته میشود (به این معنی که به کندی رشد میکند و به کندی گسترش مییابد). این نوع به بافتهای مجاور رشد میکند و گاهی اوقات میتواند به نقاط دور دست بدن گسترش یابد. ممکن است در بافتهای نرم یا اندامهای داخلی مانند کبد یا ریهها شروع شود.

- فیبروسارکوم نوزادی (Infantile fibrosarcoma) شایع ترین سارکوم بافت نرم در کودکان زیر یک سال است. تمایل به رشد آهسته دارد و نسبت به فیبروسارکوم بزرگسالان احتمال انتشار آن به سایر اندامها کمتر است.
- تومورهای فیبری منفرد (Solitary fibrous tumors) اغلب خوش خیم هستند (سرطانی نیستند) اما برخی نیز سرطانی (بدخیم) اند. برخی از آنها از ران، زیر بغل و لگن شروع میشود. آنها همچنین میتوانند از بافت پوشاننده ریهها (به نام پلور یا pleura) شروع شوند. بسیاری از تومورهایی که زمانی همانژیوپری سیتوما (hemangiopericytomas) نامیده میشدند، امروزه به عنوان تومورهای فیبری منفرد در نظر گرفته میشوند.
تومورهای خوش خیم بافت نرم
بسیاری از تومورهای خوش خیم (غیر سرطانی) میتوانند در بافتهای نرم شروع شوند. این شامل:
- الاستوفیبروم (Elastofibromas): تومورهای خوش خیم بافت فیبری
- فیبروم (Fibromas): تومورهای خوش خیم بافت فیبری
- هیستیوسیتومهای فیبری (Fibrous histiocytomas): تومورهای خوش خیم بافت فیبری
- تومورهای گلوموس (Glomus tumors): تومورهای خوش خیمی که در نزدیکی رگهای خونی ایجاد میشوند.
- تومورهای سلولی دانه ای یا گرانولی (Granular cell tumors): معمولاً تومورهای خوش خیم در بزرگسالان که اغلب از زبان شروع میشوند اما تقریباً در هر نقطه از بدن یافت میشوند.
- همانژیوم (Hemangiomas): تومورهای خوش خیم عروق خونی
- هیبرنوما (Hibernomas): تومورهای خوش خیم بافت چربی
- لیپومها (Lipomas): تومورهای خوش خیم بسیار شایع بافت چربی
- لیومیوم (Leiomyomas): تومورهای خوش خیم عضله صاف که در هر جایی از بدن یافت میشوند. آنها در دیوارههای رحم بسیار رایج هستند، جایی که به عنوان فیبروم شناخته میشوند.
- لیپوبلاستوم (Lipoblastomas): تومورهای خوش خیم بافت چربی که اغلب در کودکان دیده میشوند.
- لنفانژیوم (Lymphangiomas): تومورهای خوش خیم عروق لنفاوی
- میکسوم (Myxomas): تومورهای خوش خیم که معمولاً در ماهیچهها هستند اما از سلولهای عضلانی شروع نمیشوند.

- نوروفیبروم (Neurofibromas): تومورهای بافت عصبی که معمولاً خوش خیم هستند. نوروفیبروم اعصاب بزرگ (Neurofibromas of large nerves)، مانند اعصاب بالای بازو یا گردن، میتواند به سرطان تبدیل شود. نوروفیبرومها در افراد مبتلا به یک بیماری ارثی به نام نوروفیبروماتوز یا neurofibromatosis (که بیماری فون رکلینهاوزن یا Recklinghausen disease نیز نامیده میشود) بسیار شایع است. آنها در افراد غیر مبتلا به این بیماری بسیار کمتر شایع هستند.
- نوروما (Neuromas): تومورهای خوش خیم اعصاب که میتوانند دردناک باشند.
- PEComas: خانواده ای از تومورها که از سلولهای غیر طبیعی به نام سلولهای اپیتلیال دور عروقی (perivascular epithelial cells) تشکیل شده است. اگرچه بیشتر این تومورها خوش خیم هستند، برخی از PEComaهای نادر بدخیم (سرطانی) هستند. شایع ترین انواع PEComas آنژیومیولیپومها و لنفانژیولیومیومها هستند. آنژیومیولیپوما (Angiomyolipoma) یک تومور خوش خیم است که اغلب کلیه را درگیر میکند. لنفانژیولیومیوماتوز (Lymphangioleiomyomatosis یا LAM) یک بیماری نادر در زنان است که در آن بسیاری از تومورهای لنفانژیولیومیوم در بافت ریه رشد کرده و در عملکرد ریه اختلال ایجاد میکنند.
- رابدومیوم (Rhabdomyomas): تومورهای خوش خیم عضله اسکلتی و قلب
- شوانوما (Schwannomas یا neurilemmomas): تومورهای خوش خیم سلولهایی که اعصاب را میپوشانند.
- تومورهای سلول غول پیکر تنوسینوویال یا Tenosynovial giant cell tumors (که تنوسینوویت ندولار یا nodular tenosynovitis نیز نامیده میشود): تومورهای خوش خیم بافت مفصلی
تومورهای سلول دوکی (Spindle cell tumors)

تومور سلول دوکی و سارکوم سلول دوکی نامهای توصیفی هستند که وقتی سلولهای تومور در زیر میکروسکوپ بلند و باریک به نظر میرسند، استفاده میشوند. تومور سلول دوکی یک تشخیص خاص یا نوع خاصی از سرطان نیست. تومور ممکن است یک سارکوم یا سارکوماتوئید (sarcomatoid) باشد – به معنای نوع دیگری از تومور (مانند کارسینوم) که در زیر میکروسکوپ شبیه یک سارکوم است.
عارضههای تومور مانند بافت نرم
برخی از تغییرات در بافتهای نرم به دلیل التهاب یا آسیب ایجاد میشوند و میتوانند توده ای شبیه تومور بافت نرم ایجاد کنند. برخلاف یک تومور واقعی، آنها از یک سلول غیر طبیعی منشأ نمیگیرند، توانایی محدودی برای رشد یا انتشار به بافتهای مجاور دارند و هرگز به سایر قسمتهای بدن سرایت نمیکنند. فاسییت ندولار (Nodular fasciitis) و میوزیت استخوانی (myositis ossificans) 2 نمونه هستند. آنها به ترتیب بر بافتهای زیر پوست و بافتهای ماهیچه ای تأثیر میگذارند.
آمارهای کلیدی برای سارکوم بافت نرم
برآوردهای انجمن سرطان آمریکا برای سارکوم بافت نرم در ایالات متحده برای سال 2023 عبارتند از:
- حدود 13400 سارکوم بافت نرم جدید تشخیص داده خواهد شد (7400 در مردان و 6000 در زنان).
- انتظار میرود حدود 5140 نفر (2720 مرد و 2420 زن) بر اثر سارکوم بافت نرم بمیرند.
این آمار شامل بزرگسالان و کودکان میشود.
شایع ترین انواع سارکوم در بزرگسالان عبارتند از:
- سارکوم پلئومورفیک تمایز نیافته (که قبلا هیستیوسیتوم فیبری بدخیم نامیده میشد)
- لیپوسارکوم
- لیومیوسارکوم
انواع خاصی بیشتر از سایرین در قسمتهای خاصی از بدن رخ میدهند. به عنوان مثال، لیومیوسارکوم شایع ترین نوع سارکوم است که در شکم یافت میشود، در حالی که لیپوسارکومها و سارکومهای پلئومورفیک تمایز نیافته بیشتر در پاها دیده میشوند. اما ممکن است پاتولوژیستها (پزشکانی که در تشخیص سرطانها بر اساس ظاهر آنها در زیر میکروسکوپ تخصص دارند)، همیشه در مورد نوع دقیق سارکوم توافق نداشته باشند. سارکوم از نوع نامشخص بسیار شایع است.
علائم و نشانههای سارکوم بافت نرم
حدود نیمی از سارکومهای بافت نرم از بازو یا پا شروع میشوند. اکثر مردم متوجه توده ای میشوند که در طول زمان (هفته تا ماه) رشد کرده است. توده ممکن است درد داشته باشد یا نداشته باشد.
هنگامی که سارکومها در پشت شکم رشد میکنند (صفاق خلفی)، علائم اغلب ناشی از مشکلات دیگری است که تومور آنها را ایجاد میکند. به عنوان مثال، ممکن است باعث انسداد یا خونریزی معده یا روده شوند. آنها میتوانند به اعصاب، رگهای خونی یا اندامهای مجاور فشار وارد کنند. آنها میتوانند به اندازه ای بزرگ شوند که تومور در شکم احساس شود. گاهی اوقات تومورها باعث درد میشوند. حدود 4 مورد از 10 مورد سارکوم در شکم شروع میشود.
در موارد نادر، سارکوم میتواند از قفسه سینه یا در سر یا گردن شروع شود.
اگر هر یک از این مشکلات را دارید، فورا به پزشک مراجعه کنید:
- یک توده جدید یا یک توده در حال رشد (در هر نقطه از بدن شما)
- درد شکمی که در حال بدتر شدن است
- وجود خون در مدفوع یا استفراغ
- مدفوع سیاه و قیری (زمانی که خونریزی در معده یا روده اتفاق میافتد، خون در هنگام هضم میتواند سیاه شود و ممکن است مدفوع را بسیار سیاه و چسبنده کند).
این علائم اغلب ناشی از چیزهایی غیر از سارکوم است اما باز هم باید توسط پزشک بررسی شود.
چه چیزی باعث سارکوم بافت نرم میشود؟
دانشمندان دقیقاً نمیدانند چه چیزی باعث بیشتر سارکومهای بافت نرم میشود اما برخی از عوامل خطرزا را پیدا کرده اند که میتوانند احتمال ابتلای فرد به این سرطانها را افزایش دهند. تحقیقات نشان داده است که برخی از این عوامل خطرزا بر ژنهای سلولهای بافت نرم تأثیر میگذارند.
محققان در درک اینکه چگونه تغییرات خاصی در DNA (قطعههای ژن) میتواند باعث سرطان شدن سلولهای طبیعی شود، پیشرفت زیادی کرده اند. DNA تقریباً دستورالعمل هر کاری را که سلولهای ما انجام میدهند، با خود حمل میکند. ما معمولا شبیه والدین خود هستیم زیرا آنها منبع DNA ما هستند. اما DNA چیزی بیش از ظاهر ما را تحت تأثیر قرار میدهد.
DNA از ژن ساخته شده است. ژنها حاوی دستور العملهایی برای ساخت پروتئینها هستند، مولکولهایی که همه عملکردهای سلول را کنترل میکنند. برخی از ژنها حاوی دستورالعملهایی برای پروتئینهایی هستند که زمان رشد و تقسیم سلولهای ما را کنترل میکنند.
- ژنهای خاصی که تقسیم سلولی را تقویت میکنند، انکوژن (oncogenes) نامیده میشوند.
- سایر مواردی که تقسیم سلولی را کند میکنند یا باعث میشوند سلولها در زمان مناسب بمیرند، ژنهای سرکوبگر تومور (tumor suppressor genes) نامیده میشوند.
سرطانها میتوانند به دلیل جهشهای DNA (نقص) ایجاد شوند که انکوژنها را فعال میکنند یا ژنهای سرکوب کننده تومور را خاموش میکنند.
بسیاری از سندرمهای سرطان خانوادگی یافت شدهاند که در آنها جهشهای ارثی DNA باعث خطر بسیار بالایی برای ابتلا به سرطان سینه، روده بزرگ، کلیه، چشم یا سایر سرطانها میشوند. برخی از این سندرمها همچنین با افزایش خطر ابتلا به سارکوم بافت نرم مرتبط هستند. (این سندرمها در مبحث عوامل خطرزا برای سارکومهای بافت نرم ذکر شده اند) این سندرمها به دلیل نقص (جهش) در ژنهایی ایجاد میشوند که میتوانند از والدین به ارث برده شوند. برخی از این نقصهای ژنی را میتوان از طریق آزمایش یافت.
جهش DNA در سارکوم بافت نرم شایع است اما آنها معمولاً در طول زندگی به دست میآیند تا اینکه قبل از تولد به ارث رسیده باشند. جهشهای اکتسابی ممکن است در اثر قرار گرفتن در معرض تشعشعات یا مواد شیمیایی سرطانزا ایجاد شوند. در بیشتر سارکومها، بدون دلیل ظاهری رخ میدهند.
محققان هنوز نمیدانند که چرا بیشتر سارکومهای بافت نرم در افرادی ایجاد میشوند که هیچ فاکتور خطر آشکاری ندارند.
عوامل خطرزا برای سارکوم بافت نرم
عامل خطرزا هر چیزی است که شانس ابتلا به بیماری مانند سرطان را تغییر دهد. سرطانهای مختلف عوامل خطرزا متفاوتی دارند. به عنوان مثال، قرار گرفتن در معرض نور شدید خورشید یک عامل خطرزا برای سرطان پوست است. سیگار یک عامل خطرزا برای سرطانهای ریه و بسیاری از سرطانهای دیگر است. اما عوامل خطرزا همه چیز را به ما نمیگوید.
داشتن یک عامل خطرزا یا حتی بسیاری از آنها به این معنی نیست که به سرطان مبتلا خواهید شد. همچنین بسیاری از افراد بدون داشتن یک عامل خطرزا به سرطان مبتلا میشوند.
عوامل آسیب زا و سبک زندگی مانند سیگار کشیدن، رژیم غذایی و ورزش با خطر ابتلا به سارکوم بافت نرم مرتبط نیستند اما موضوع مصدومیت در گذشته باعث سردرگمی شده است. یکی از دلایل این است که ناحیه آسیب دیده ممکن است متورم شود.
این تورم میتواند شبیه یک تومور باشد اما این چنین نیست. همچنین، هنگامی که آسیب میبینید، درد ممکن است توجه شما را به ناحیه آسیب دیده جلب کند. پزشک ممکن است ناحیه مورد نظر را بررسی کند و اشعه ایکس یا سایر مطالعات تصویر برداری ممکن است انجام شود. این میتواند احتمال کشف هر سارکومی را که در آن جا وجود دارد، بیشتر کند، حتی اگر مدتی در آن جا وجود داشته باشد.
با این حال، دانشمندان چند عامل خطرزا را پیدا کرده اند که احتمال ابتلای فرد به سارکوم بافت نرم را افزایش میدهد:
پرتو درمانی برای درمان سایر سرطانها
قرار گرفتن در معرض پرتو درمانی کمتر از 5 درصد از سارکومها را تشکیل میدهد اما بیماران ممکن است در اثر تشعشعات داده شده برای درمان سرطانهای دیگر، مانند سرطان سینه یا لنفوم، سارکوم ایجاد کنند. سارکوم اغلب در قسمتی از بدن که تحت درمان با اشعه قرار گرفته شروع میشود. میانگین زمان بین پرتو درمانی و تشخیص سارکوم حدود 10 سال است.
تکنیکهای پرتو درمانی در طی چندین دهه به طور پیوسته بهبود یافته اند. درمانها اکنون سرطانها را با دقت بیشتری هدف قرار میدهند و اطلاعات بیشتری در مورد انتخاب دوزهای تشعشعی وجود دارد. انتظار میرود این پیشرفتها تعداد سرطانهای ناشی از پرتو درمانی را کاهش دهد اما از آن جایی که توسعه این سرطانها بسیار طول میکشد، نتایج این تغییرات ممکن است برای مدت طولانی دیده نشود. با این حال، پرتو درمانی تنها زمانی مورد استفاده قرار میگیرد که مزایای آن (بهبود میزان بقا و تسکین علائم) از خطرات آن بیشتر باشد.
سندرمهای سرطان خانوادگی
سندرمهای سرطان خانوادگی اختلالاتی هستند که در اثر نقصهای ژنی (جهش) – که افراد با آن متولد میشوند (اغلب از والدین به ارث میرسند) – ایجاد میشوند که با خطر بالای ابتلا به برخی سرطانها مرتبط است. برخی از سندرمهای سرطان خانوادگی خطر ابتلا به سارکوم بافت نرم را در فرد افزایش میدهند.
نوروفیبروماتوز (Neurofibromatosis)
نوروفیبروماتوز به عنوان بیماری فون رکلینهاوزن نیز شناخته میشود. معمولاً در خانوادهها وجود دارد و باعث بسیاری از تومورهای خوشخیم (نه سرطانی) میشود که در اعصاب زیر پوست و سایر قسمتهای بدن تشکیل میشوند (اینها نوروفیبروم نامیده میشوند.) این بیماری ناشی از نقص (جهش) در ژنهای NF1 و NF2 است. حدود 5 درصد از افراد مبتلا به نوروفیبروماتوز سارکوم در نوروفیبروم ایجاد میکنند.
سندرم گاردنر (Gardner syndrome)

سندرم گاردنر بیماری ناشی از نقص در ژن APC است. این سندرم نوعی پولیپوز آدنوماتوز خانوادگی (familial adenomatous polyposis یا FAP) است و افراد مبتلا به آن پولیپهای زیادی در روده بزرگ (و رودهها) دارند و خطر ابتلا به سرطان روده بزرگ را بالا میبرند. همچنین باعث ایجاد مشکلاتی در خارج از روده بزرگ، از جمله تومورهای دسموئید میشوند. (این موارد در مبحث سارکوم بافت نرم چیست؟ توضیح داده شده است.)
سندرم Li-Fraumeni
سندرم Li-Fraumeni به دلیل نقص ارثی در ژن TP53 ایجاد میشود. افراد مبتلا به این سندرم در معرض خطر بالایی برای سرطان مانند سرطان سینه، تومورهای مغزی، لوسمی و سارکوم هستند. با این حال، تنها 10 تا 20 مورد از هر 100 نفر مبتلا به سندرم Li-Fraumeni به سارکوم بافت نرم مبتلا میشوند. افراد مبتلا به این سندرم به اثرات سرطان زا پرتو حساس هستند. بنابراین اگر سرطانی داشته باشند که با پرتو درمانی درمان شده باشد، شانس بسیار بالایی برای ایجاد سرطان جدید در بخشی از بدن که تحت درمان قرار گرفته است، دارند.
رتینوبلاستوما (Retinoblastoma)
رتینوبلاستوما یک سرطان چشم در کودکان است که میتواند به دلیل نقص در ژن RB1 ایجاد شود. کودکان مبتلا به این نقص ژنی نیز در معرض خطر بیشتری برای ایجاد سارکوم استخوان یا بافت نرم هستند، به خصوص اگر رتینوبلاستوما با پرتو درمانی درمان شده باشد.
سندرم ورنر (Werner syndrome)
سندرم ورنر به دلیل نقص در ژن RECQL2 ایجاد میشود. کودکان مبتلا به این سندرم مشکلاتی مانند آن چه در افراد مسن دیده میشود دارند. اینها شامل آب مروارید، تغییرات پوستی و گرفتگی عروق قلب (تصلب شرایین) است که میتواند منجر به حملات قلبی شود. آنها همچنین خطر ابتلا به سرطان از جمله سارکوم بافت نرم را افزایش میدهند.
سندرم گورلین (Gorlin syndrome)
به سندرم گورلین، سندرم کارسینوم سلول بازال نووید (nevoid basal cell carcinoma syndrome یا NBCCS) نیز گفته میشود. این بیماری به دلیل نقص در ژن PTCH1 ایجاد میشود. افراد مبتلا به این سندرم در معرض خطر بالایی برای ابتلا به بسیاری از سرطانهای سلول بازال پوست (basal cell skin cancers) هستند. آنها همچنین خطر ابتلا به فیبروسارکوم و رابدومیوسارکوم را افزایش میدهند.
توبروس اسکلروزیس (Tuberous sclerosis)
توبروس اسکلروزیس میتواند به دلیل نقص در ژن TSC1 و یا TSC2 ایجاد شود. افراد مبتلا به این سندرم اغلب دچار تشنج و مشکلات یادگیری میشوند. آنها تومورهای خوش خیم (نه سرطانی) را در بسیاری از اندامهای مختلف دریافت میکنند. آنها همچنین مشکلات کلیوی، اغلب همراه با تومور کلیه به نام آنژیومیولیپوما دارند. افراد مبتلا به توبروس اسکلروزیس در معرض خطر ابتلا به رابدومیوسارکوم هستند.
سیستم لنفاوی آسیب دیده
لنف (Lymph) یک مایع شفاف حاوی سلولهای سیستم ایمنی است که توسط یک سری رگهای لنفاوی در سراسر بدن حمل میشود. این عروق گرههای (غدد) لنفاوی (مجموعههای کوچک لوبیا شکل از سلولهای سیستم ایمنی) را به هم متصل میکنند. هنگامی که غدد لنفاوی توسط پرتو درمانی برداشته یا آسیب دیده اند، مایع لنفاوی میتواند ایجاد شده و باعث تورم شود. به این عارضه ادم لنفاوی (lymphedema) میگویند.
لنفانژیوسارکوم (تومور بدخیم یا سرطانی که در عروق لنفاوی ایجاد میشود) عارضه بسیار نادر ادم لنفاوی مزمن است.
مواد شیمیایی
قرار گرفتن در معرض وینیل کلراید (vinyl chloride، یک ماده شیمیایی که در ساخت پلاستیک استفاده میشود) یک عامل خطرزا برای ایجاد سارکوم کبد است اما ثابت نشده است که باعث ایجاد سارکوم بافت نرم میشود.
آرسنیک (Arsenic) همچنین با نوعی سارکوم کبدی مرتبط است اما نه با سارکوم بافت نرم. قرار گرفتن در معرض دیوکسین (dioxin) و علفکشهایی که حاوی فنوکسی استیک اسید (phenoxyacetic acid) در دوزهای بالا هستند (مانند افرادی که در مزرعهها کار میکنند) نیز ممکن است از عوامل خطرزا باشد اما این به طور قطع مشخص نیست. هیچ مدرکی مبنی بر اینکه علفکشها (قاتل علفهای هرز) یا حشرهکشها، در سطوحی که عموم مردم با آن مواجه هستند، باعث ایجاد سارکوم میشوند، وجود ندارد.
آیا سارکومهای بافت نرم میتوانند زودتر پیدا شوند؟
افرادی که سابقه خانوادگی قوی سارکوم بافت نرم دارند یا در جوانی سرطانهای دیگری داشته اند، ممکن است بخواهند با پزشک در مورد مزایا و معایب آزمایش ژنتیک صحبت کنند. نتایج آزمایش همیشه باید توسط یک مشاور ژنتیک یا یک پزشک آموزش دیده خاص توضیح داده شود که میتواند نتایج را تفسیر کند و به بیماران پرخطر در مورد نیاز به آزمایشهای تشخیص زود هنگام سرطان توصیه کند.
خانوادههایی با سابقه بیماریهای ارثی خاص ناشی از نقص در ژنهای خاص، خطر ابتلا به سارکوم بافت نرم را افزایش میدهند. ژنهای تغییر یافته (جهش یافته) را میتوان با آزمایش ژنتیکی تشخیص داد، بنابراین اعضای خانواده باید این گزینه را با پزشک خود در میان بگذارند. همچنین در صورت مشاهده هرگونه توده یا رشد باید فوراً به پزشک مراجعه کنند.
هیچ آزمایش و معاینه غربالگری برای افرادی که سابقه خانوادگی سارکوم یا سایر عوامل خطرزا سارکوم را ندارند، توصیه نمیشود. برای این افراد، بهترین رویکرد برای تشخیص زود هنگام این است که به ارائه دهنده مراقبتهای بهداشتی خود در مورد هرگونه توده یا رشد غیر قابل توضیح یا سایر علائمی که ممکن است توسط سارکوم بافت نرم ایجاد شود، اطلاع دهند.
آزمایش برای سارکوم بافت نرم
اگر نشانه یا علائمی دارید که نشان میدهد ممکن است سارکوم بافت نرم داشته باشید، پزشک احتمالاً باید آزمایشاتی را انجام دهد تا بفهمد سرطان دارید یا خیر.
سابقه پزشکی و معاینه فیزیکی
پزشک در مورد سابقه پزشکی شما، از جمله سابقه خانوادگی شما میپرسد تا بفهمد که آیا شما هر یک از عوامل خطرزا احتمالی را دارید یا خیر. همچنین از شما در مورد علائم خود سؤال میشود، مانند زمان شروع آنها و مدت زمانی که آنها را داشته اید.
تستهای تصویر برداری
تستهای تصویر برداری از امواج صوتی، اشعه ایکس، میدانهای مغناطیسی یا مواد رادیواکتیو برای ایجاد تصاویری از داخل بدن شما استفاده میکنند. آزمایشات تصویر برداری ممکن است به دلایل مختلفی انجام شود، مانند:
- برای بررسی مناطق مشکوک که ممکن است سرطان باشند.
- برای دیدن اینکه آیا سرطان گسترش یافته است یا خیر.
- برای کمک به تعیین اینکه آیا روند درمان موثر است یا خیر.
اشعه ایکس ساده
عکس برداری منظم با اشعه ایکس از ناحیه دارای توده ممکن است اولین آزمایش درخواستی باشد. ممکن است پس از تشخیص، عکس برداری با اشعه ایکس قفسه سینه انجام شود تا مشخص شود که آیا سارکوم به ریهها سرایت کرده است یا خیر.
سی تی اسکن (توموگرافی کامپیوتری یا computed tomography)
سی تی اسکن از اشعه ایکس برای ایجاد تصاویر مقطعی دقیق از بدن شما استفاده میکند. این آزمایش اغلب در صورتی انجام میشود که پزشک مشکوک به سارکوم بافت نرم در قفسه سینه، شکم یا صفاق خلفی (پشت شکم) باشد. این آزمایش همچنین برای بررسی اینکه آیا سارکوم به ریهها، کبد یا سایر اندامها گسترش یافته است یا خیر نیز استفاده میشود.

سی تی اسکن ممکن است برای هدایت سوزن بیوپسی به داخل تومور داخل بدن – برای مثال قفسه سینه یا شکم – استفاده شود. به این بیوپسی سوزنی هدایت شده با CT (CT-guided needle biopsy) میگویند. (برای اطلاعات بیشتر در مورد بیوپسی به مباحث زیر مراجعه کنید.) در حالی که رادیولوژیست سوزن بیوپسی را به سمت تومور حرکت میدهد، روی میز سی تی اسکن دراز میکشید. سی تی اسکن تا زمانی که پزشکان مطمئن شوند که سوزن داخل تومور است، تکرار میشود.
ام آر آی (تصویر برداری رزونانس مغناطیسی یا magnetic resonance imaging)
MRI از امواج رادیویی و آهنرباهای قوی به جای اشعه ایکس برای گرفتن عکس از بدن استفاده میکند. اسکن MRI اغلب بخشی از کار بر روی هر توموری است که میتواند سارکوم باشد. آنها اغلب بهتر از سی تی اسکن در ارزیابی سارکوم در بازوها یا پاها هستند.

MRI تصویر خوبی از وسعت تومور ارائه میدهد. این میتواند به تیم مراقبتهای بهداشتی شما چیزهای زیادی در مورد تومور نشان دهد، مانند اینکه کجاست، چقدر بزرگ است و گاهی اوقات حتی نوع بافتی که از آن میآید (مانند استخوان، چربی یا ماهیچه). MRI همچنین در بررسی مغز و نخاع بسیار مفید است.
سونوگرافی (Ultrasound)
اولتراسوند از امواج صوتی و پژواک آنها برای تولید تصاویری از قسمتهای بدن استفاده میکند. ابزار کوچکی به نام مبدل امواج صوتی را میفرستد و پژواکها را در حین بازگشت از اندامها دریافت میکند. سپس یک کامپیوتر أمواج برگشتی را به یک تصویر روی صفحه تبدیل میکند.
سونوگرافی ممکن است قبل از بیوپسی انجام شود تا ببیند آیا توده کیست است، به این معنی که آیا مایع در آن وجود دارد و احتمالاً سرطانی نیست یا اینکه آیا جامد است و به احتمال زیاد تومور است. اگر CT یا MRI انجام شده باشد، اغلب به این آزمایش نیازی نیست.
اسکن PET (توموگرافی گسیل پوزیترون یا positron emission tomography)
اسکنهای PET از نوعی قند رادیو اکتیو استفاده میکنند که وارد خون میشود. از آن جایی که سرطانها از گلوکز (قند) با سرعت بیشتری نسبت به بافتهای طبیعی استفاده میکنند، این قند رادیو اکتیویته در سرطان جمع میشود. سپس یک اسکنر میتواند رسوبات رادیو اکتیو را شناسایی کند.
اسکن PET زمانی مفید است که پزشک فکر میکند سرطان گسترش یافته است اما نمیداند این گسترش در کجاست.
می توان از آن به جای بسیاری از اشعه ایکس مختلف استفاده کرد زیرا کل بدن شما را اسکن میکند. اغلب از اسکن PET با سی تی اسکن (به نام اسکن PET/CT) استفاده میشود. این کمک میکند تا تصمیم بگیرید که آیا تغییراتی که در سی تی اسکن مشاهده میشود سرطان هستند یا چیز دیگری وجود دارد. PET اغلب برای سارکوم استفاده نمیشود اما در برخی موارد میتواند مفید باشد.
بیوپسی یا نمونه برداری (biopsy)
اگر فردی بر اساس معاینات و آزمایشات تصویر برداری مشکوک به سارکوم بافت نرم باشد، بیوپسی لازم است تا مطمئن شویم که این یک سارکوم است و نه نوع دیگری از سرطان یا یک بیماری خوش خیم (نه سرطانی). در بیوپسی، پزشک یک قطعه کوچک از تومور را خارج میکند. این بافت زیر میکروسکوپ بررسی میشود و ممکن است تستهای آزمایشگاهی دیگری نیز انجام شود.
انواع مختلفی از بیوپسی برای تشخیص سارکوم استفاده میشود. پزشکان با تجربه در زمینه این تومورها یکی را بر اساس اندازه و محل تومور انتخاب میکنند. اغلب ترجیح میدهند از آسپیراسیون با سوزن ظریف (fine needle aspiration) یا بیوپسی با سوزن مرکزی (core needle biopsy) به عنوان اولین گام استفاده کنند.
ممکن است بخواهید در مورد تجربه جراح خود در انجام بیوپسی بپرسید. تکنیک بیوپسی مناسب بخش بسیار مهمی در درمان موفقیت آمیز سارکوم بافت نرم است. بیوپسی نامناسب میتواند منجر به گسترش تومور و مشکلاتی در برداشتن تومور در آینده شود.
مراحل سارکوم بافت نرم
پس از تشخیص سارکوم بافت نرم در فردی، پزشکان سعی میکنند بفهمند که آیا بیماری گسترش یافته است یا خیر و اگر چنین است، این گسترش تا کجاست. این فرآیند مرحله بندی (staging) نامیده میشود. مرحله سرطان، میزان سرطان در بدن را توصیف میکند. این به تعیین اینکه سرطان چقدر جدی است و بهترین روش درمان آن کمک میکند. پزشکان همچنین هنگام صحبت در مورد آمار بقا از مرحله سرطان استفاده میکنند.
مراحل سارکوم بافت نرم از مراحل I (1) تا IV (4) متغیر است. به عنوان یک قاعده، هرچه این عدد کمتر باشد، سرطان کمتر گسترش یافته است. عدد بالاتر، مانند مرحله IV، به معنای گسترش بیشتر سرطان است. در یک مرحله، حرف قبل به معنای مرحله پایین تر است. اگرچه تجربه سرطان هر فرد منحصربهفرد است، سرطانهایی که مراحل مشابهی دارند، چشم انداز مشابهی نیز دارند و اغلب به روشی مشابه درمان میشوند.
مرحله چگونه تعیین میشود؟
سیستم مرحله بندی که اغلب برای سارکوم بافت نرم استفاده میشود، سیستم TNM کمیته مشترک سرطان آمریکا (American Joint Committee on Cancer یا AJCC) است که بر اساس 4 اطلاعات کلیدی است:
- وسعت تومور (T): اندازه سرطان چقدر است؟
- گسترش به غدد لنفاوی مجاور (N): آیا سرطان به غدد لنفاوی مجاور سرایت کرده است؟
- گسترش (متاستاز) به نقاط دور دست (M): آیا سرطان به اندامهای دور مانند ریهها گسترش یافته است؟
- درجه (G) سرطان: سلولهای سارکوم چقدر شبیه سلولهای طبیعی هستند؟
مرحله یا درجه
درجه تا حدی برای تعیین مرحله سارکوم استفاده میشود. سیستم مرحله بندی سارکومها را به 3 درجه (1 تا 3) تقسیم میکند. درجه یک سارکوم به پیش بینی سرعت رشد و گسترش آن کمک میکند. همچنین در پیش بینی چشم انداز بیمار مفید است و به تعیین گزینههای درمانی کمک میکند.
درجه یک سارکوم با استفاده از سیستمی به نام سیستم فرانسوی (French) یا FNCLCC تعیین میشود و بر اساس 3 عامل است:
- تمایز (Differentiation): به سلولهای سرطانی امتیازی از 1 تا 3 داده میشود، زمانی که 1 بسیار شبیه سلولهای طبیعی به نظر میرسند و 3 زمانی که سلولهای سرطانی بسیار غیر طبیعی به نظر میرسند، استفاده میشود. به انواع خاصی از سارکوم به طور خودکار نمره بالاتری داده میشود.
- تعداد میتوز (Mitotic count): چند سلول سرطانی در حال تقسیم زیر میکروسکوپ دیده میشود. امتیاز از 1 تا 3 داده میشود (نمره کمتر به این معنی است که سلولهای کمتری در حال تقسیم دیده میشوند).
- نکروز تومور (Tumor necrosis): چه مقدار از تومور از بافت در حال مرگ تشکیل شده است. از 0 تا 2 نمره داده میشود (نمره کمتر به این معنی است که بافت در حال مرگ کمتری وجود دارد).
به هر عامل یک امتیاز داده میشود و امتیازها برای تعیین درجه تومور اضافه میشوند. سارکومهایی که دارای سلولهایی هستند که طبیعیتر به نظر میرسند و سلولهای کمتری در آنها تقسیم میشوند، معمولاً در دستههای با درجه پایین قرار میگیرند. تومورهای درجه پایین نسبت به تومورهای درجه بالاتر به کندی رشد میکنند، آهسته تر گسترش مییابند و اغلب چشم انداز (پیش آگهی) بهتری دارند. به انواع خاصی از سارکوم به طور خودکار نمره تمایز بالاتری داده میشود. این موضوع آنقدر بر نمره کلی تأثیر میگذارد که هرگز نمره پایین در نظر گرفته نمیشوند. نمونههایی از این موارد عبارتند از سارکوم سینوویال (synovial sarcomas) و سارکوم جنینی (embryonal sarcomas). معنی اعداد نمرات چیست:
GX: نمره قابل ارزیابی نیست (به دلیل اطلاعات ناقص).
درجه 1 (G1): نمره کل 2 یا 3
درجه 2 (G2): نمره کل 4 یا 5
درجه 3 (G3): نمره کل 6، 7 یا 8
تعریف TNM
بسته به اینکه سرطان در کجای بدن قرار دارد، سیستمهای مرحله بندی مختلفی برای سارکوم بافت نرم وجود دارد.
- سر و گردن
- تنه و اندامها (بازوها و پاها)
- اندامهای احشایی شکم و قفسه سینه (سینه).
- صفاق خلفی
اعداد یا حروف بعد از T، N و M جزئیات بیشتری در مورد هر یک از این عوامل ارائه میدهند. اعداد بالاتر به معنای پیشرفته تر بودن سرطان است. هنگامی که دسته بندیهای T، N و M یک فرد مشخص شد، این اطلاعات در فرآیندی به نام گروه بندی مرحله ای (stage grouping) با یکدیگر ترکیب میشوند تا یک مرحله کلی را تعیین کنند.
از 4 مکان اصلی، تنها 2 مکان (تنه و اندامها و خلف صفاق) دارای گروه بندی مرحله ای هستند.
سیستم مرحله بندی زیر از مرحله پاتولوژیک یا pathologic stage (که مرحله جراحی یا surgical stage نیز نامیده میشود) استفاده میکند. این مرحله با بررسی بافت برداشته شده در طی یک عمل مشخص میشود. گاهی اوقات، اگر جراحی بلافاصله یا اصلا امکان پذیر نباشد، به جای آن سرطان یک مرحله بالینی (clinical stage) داده میشود.
این بر اساس نتایج یک معاینه فیزیکی، بیوپسی و تستهای تصویر برداری است. مرحله بالینی برای کمک به برنامه ریزی درمان استفاده خواهد شد. با این حال، گاهی اوقات سرطان فراتر از تخمینهای مرحله بالینی گسترش یافته است و ممکن است چشم انداز بیمار را به دقت یک مرحله پاتولوژیک پیش بینی نکند.
سیستمی که در زیر توضیح داده شده، جدیدترین سیستم AJCC است که در ژانویه 2018 اجرا شد. مرحله بندی سرطان میتواند پیچیده باشد، بنابراین از پزشک خود بخواهید که آن را به روشی که شما درک میکنید برایتان توضیح دهد.
مراحل سارکوم تنه و اندامها
مرحله IA (T1، N0، M0 و G1 یا GX)
سرطان 5 سانتی متر (2 اینچ) یا کوچکتر (T1) است.
به غدد لنفاوی مجاور (N0) یا به نقاط دور دست (M0) سرایت نکرده است. سرطان درجه 1 (G1) است یا درجه آن قابل ارزیابی نیست (GX).
مرحله IB (T2، T3، T4، N0، M0، G1 یا GX)
سرطان عبارت است از:
- بزرگتر از 5 سانتی متر اما نه بیشتر از 10 سانتی متر (T2) یا
- بزرگتر از 10 سانتی متر اما نه بیشتر از 15 سانتی متر (T3) یا
- بزرگتر از 15 سانتی متر (T4).
به غدد لنفاوی مجاور (N0) یا به نقاط دور دست (M0) سرایت نکرده است. سرطان درجه 1 (G1) است یا درجه آن قابل ارزیابی نیست (GX).
مرحله II (T1، N0، M0، G2 یا G3)
سرطان 5 سانتی متر (2 اینچ) یا کوچکتر (T1) است.
به غدد لنفاوی مجاور (N0) یا به نقاط دور دست (M0) سرایت نکرده است. سرطان درجه 2 (G2) یا درجه 3 (G3) است.
مرحله IIIA (T2، N0، M0، G2 یا G3)
سرطان بزرگتر از 5 سانتی متر (2 اینچ) است اما بیش از 10 سانتی متر (T2) نیست.
به غدد لنفاوی مجاور (N0) یا به نقاط دور دست (M0) سرایت نکرده است. سرطان درجه 2 (G2) یا درجه 3 (G3) است.
مرحله IIIB (T3 یا T4، N0، M0، G2 یا G3)
سرطان عبارت است از:
- بزرگتر از 10 سانتی متر اما نه بیشتر از 15 سانتی متر (T3) یا
- بزرگتر از 15 سانتی متر (T4).
به غدد لنفاوی مجاور (N0) یا به نقاط دور دست (M0) سرایت نکرده است. سرطان درجه 2 (G2) یا درجه 3 (G3) است.
مرحله IV (هر T، N1، M0، هر G)
سرطان هر اندازه باشد (هر T) و به غدد لنفاوی مجاور (N1) گسترش یافته است.
به مکانهای دور سرایت نکرده است (M0). میتواند هر درجه ای باشد.
یا
(هر T، هر N، M1، هر G)
سرطان هر اندازه باشد (هر T) و به غدد لنفاوی مجاور (N1) گسترش یافته است.
به مکانهای دور مانند ریهها (M1) گسترش یافته است. میتواند هر درجه ای باشد.
*دستههای زیر در بالا فهرست نشده اند:
- TX: تومور اصلی به دلیل کمبود اطلاعات قابل ارزیابی نیست.
- T0: شواهدی از تومور اولیه وجود ندارد.
- NX: غدد لنفاوی منطقه ای به دلیل کمبود اطلاعات قابل ارزیابی نیستند.
مراحل سارکوم صفاق خلفی
مرحله بندی AJCC
مرحله IA (T1، N0، M0، G1 یا GX)
سرطان 5 سانتی متر (2 اینچ) یا کوچکتر (T1) است.
به غدد لنفاوی مجاور (N0) یا به نقاط دور دست (M0) سرایت نکرده است. سرطان درجه 1 (G1) است یا درجه آن قابل ارزیابی نیست (GX).
مرحله IB (T2، T3، T4، N0، M0، G1 یا GX)
سرطان:
- بزرگتر از 5 سانتی متر اما نه بیشتر از 10 سانتی متر یا
- بزرگتر از 10 سانتی متر اما نه بیشتر از 15 سانتی متر (T3) یا
- بزرگتر از 15 سانتی متر (T4).
به غدد لنفاوی مجاور (N0) یا به نقاط دور دست (M0) سرایت نکرده است. سرطان درجه 1 (G1) است یا درجه آن قابل ارزیابی نیست (GX).
مرحله II (T1، N0، M0، G2 یا G3)
سرطان 5 سانتی متر (2 اینچ) یا کوچکتر (T1) است.
به غدد لنفاوی مجاور (N0) یا به نقاط دور دست (M0) سرایت نکرده است. سرطان درجه 2 (G2) یا درجه 3 (G3) است.
مرحله IIIA (T2، N0، M0، G2 یا G3)
سرطان بزرگتر از 5 سانتی متر (2 اینچ) است اما بیش از 10 سانتی متر (T2) نیست.
به غدد لنفاوی مجاور (N0) یا به نقاط دور دست (M0) سرایت نکرده است. سرطان درجه 2 (G2) یا درجه 3 (G3) است.
مرحله IIIB (T3 یا T4، N0، M0، G2 یا G3)
سرطان عبارت است از:
- بزرگتر از 10 سانتی متر اما نه بیشتر از 15 سانتی متر (T3) یا
- بزرگتر از 15 سانتی متر (T4).
به غدد لنفاوی مجاور (N0) یا به نقاط دور دست (M0) سرایت نکرده است. سرطان درجه 2 (G2) یا درجه 3 (G3) است.
یا
(هر T، N1، M0، هر G)
سرطان هر اندازه باشد (هر T) و به غدد لنفاوی مجاور (N1) گسترش یافته است.
به مکانهای دور سرایت نکرده است (M0). میتواند هر درجه ای باشد.
مرحله IV (هر T، هر N، M1، هر G)
سرطان هر اندازه باشد (هر T) و به غدد لنفاوی مجاور (N1) گسترش یافته است.
به مکانهای دور مانند ریهها (M1) گسترش یافته است. میتواند هر درجه ای باشد.
*دستههای زیر در جدول بالا فهرست نشده اند:
- TX: تومور اصلی به دلیل کمبود اطلاعات قابل ارزیابی نیست.
- T0: شواهدی از تومور اولیه وجود ندارد.
- NX: غدد لنفاوی منطقه ای به دلیل کمبود اطلاعات قابل ارزیابی نیستند.
میزان بقا برای سارکوم بافت نرم
میزان بقا میتواند به شما این ایده را بدهد که چند درصد از افراد مبتلا به همان نوع و مرحله سرطان تا مدت معینی (معمولاً 5 سال) پس از تشخیص هنوز زنده هستند. آنها نمیتوانند به شما بگویند که چقدر زنده خواهید ماند اما ممکن است به شما کمک کنند تا درک بهتری از احتمال موفقیت روند درمان شما داشته باشید.
به خاطر داشته باشید که میزان بقا تخمینی است و اغلب بر اساس نتایج قبلی تعداد زیادی از افرادی است که سرطان خاصی داشتند اما آنها نمیتوانند پیش بینی کنند که در مورد فرد خاصی چه اتفاقی خواهد افتاد. این آمار میتواند گیج کننده باشد و ممکن است شما را به پرسیدن سوالات بیشتری سوق دهد. پزشک شما با وضعیت شما آشناست. بپرسید چگونه این اعداد ممکن است برای شما اعمال شوند.
نرخ بقای نسبی 5 ساله چیست؟
نرخ بقای نسبی افراد با همان نوع و مرحله سارکوم بافت نرم را با افراد در کل جمعیت مقایسه میکند. به عنوان مثال، اگر میزان بقای نسبی 5 ساله برای مرحله خاصی از سارکوم بافت نرم 80 درصد باشد، به این معنی است که زنده ماندن افراد مبتلا به آن سرطان برای ۵ سال پس از تشخیص نسبت به افراد سالمی که به این بیماری مبتلا نیستند، به طور متوسط حدود 80 درصد است.
این اعداد از کجا میآیند؟
انجمن سرطان آمریکا به اطلاعات پایگاه داده SEER که توسط موسسه ملی سرطان (National Cancer Institute یا NCI) نگهداری میشود، برای ارائه آمار بقای انواع مختلف سرطان متکی است.
پایگاه داده SEER نرخ بقای نسبی 5 ساله سارکوم بافت نرم در ایالات متحده را بر اساس میزان گسترش سرطان دنبال میکند. با این حال، پایگاه داده SEER سرطانها را بر اساس مراحل AJCC TNM (مرحله 1، مرحله 2، مرحله 3 و غیره) گروه بندی نمیکند. در عوض، سرطانها را به مراحل موضعی، منطقه ای و دور دسته بندی میکند:
- موضعی (Localized): سرطان محدود به قسمتی از بدن است که از آن جا شروع شده است.
- منطقه ای (Regional): سرطان به ساختارهای مجاور یا غدد لنفاوی مجاور گسترش یافته است.
- دور (Distant): سرطان به نقاط دورتر بدن مانند ریهها گسترش یافته است.
نرخ بقای نسبی 5 ساله برای سارکوم بافت نرم
بر اساس اطلاعات افراد مبتلا به سارکوم بافت نرم بین سالهای 2010 و 2016.

درک اعداد
- این اعداد فقط برای مرحله سرطان در هنگام اولین تشخیص صدق میکند. اگر سرطان رشد کند، گسترش یابد یا پس از درمان عود کند، بعداً اعمال نمیشوند.
- این اعداد همه چیز را در نظر نمیگیرند. میزان بقا بر اساس میزان گسترش سرطان گروه بندی میشود اما سن، سلامت کلی، درجه تومور، محل شروع تومور (بازو، پا یا صفاق خلفی)، میزان پاسخ سرطان به درمان و سایر عوامل نیز میتوانند روی دید شما تاثیر بگذارد.
- افرادی که اکنون مبتلا به سارکوم بافت نرم تشخیص داده میشوند، ممکن است چشم انداز بهتری نسبت به این اعداد داشته باشند. درمانها با گذشت زمان بهبود مییابند و این اعداد بر اساس اطلاعات افرادی است که حداقل پنج سال زودتر تشخیص داده شده و درمان شده اند.
درمان سارکوم بافت نرم
اگر سارکوم بافت نرم برای شما تشخیص داده شده است، تیم درمان گزینههای شما را با شما در میان میگذارد. مهم است که مزایای هر گزینه درمانی را در مقابل خطرات و عوارض جانبی احتمالی سنجید.
سارکوم بافت نرم چگونه درمان میشود؟
انواع اصلی درمان سارکوم بافت نرم عبارتند از:
جراحی (Surgery) برای سارکوم بافت نرم
جراحی معمولا برای درمان سارکوم بافت نرم استفاده میشود. بسته به محل و اندازه سارکوم، جراحی ممکن است بتواند سرطان را از بین ببرد. هدف از جراحی برداشتن کل تومور به همراه حداقل 1 تا 2 سانتی متر (کمتر از یک اینچ) از بافت طبیعی اطراف آن است. این برای اطمینان از این است که هیچ سلول سرطانی باقی نماند. هنگامی که بافت برداشته شده زیر میکروسکوپ بررسی میشود، پزشک بررسی میکند که آیا سرطان در لبهها (حاشیه) نمونه رشد میکند یا خیر.
- اگر سلولهای سرطانی در لبههای بافت برداشته شده یافت شوند، گفته میشود که دارای حاشیههای مثبت است. این بدان معنی است که سلولهای سرطانی ممکن است باقی مانده باشند. هنگامی که سلولهای سرطانی پس از جراحی باقی میمانند، ممکن است به دوره درمان بیشتری – مانند پرتو درمانی یا جراحی دیگر – نیاز باشد.
- اگر سرطان در لبههای بافت برداشته شده رشد نکند، گفته میشود که دارای حاشیههای منفی یا واضح است. اگر سارکوم با حاشیههای واضح برداشته شود، احتمال بازگشت پس از جراحی بسیار کمتر است. در این مورد، جراحی ممکن است تنها درمان مورد نیاز باشد.
هنگامی که تومور در شکم است، برداشتن آن و بافت طبیعی کافی برای به دست آوردن حاشیههای واضح میتواند سخت باشد زیرا تومور میتواند در کنار اندامهای حیاتی باشد که نمیتوان آنها را خارج کرد.
جراحی قطع عضو و حفظ اندام
در گذشته، بسیاری از سارکومهای بازوها و پاها با برداشتن اندام (آمپوتاسیون یا amputation) درمان میشدند. امروزه این کار به ندرت مورد نیاز است. در عوض، استاندارد، جراحی برای برداشتن تومور بدون قطع عضو است. به این عمل جراحی حفظ اندام (limb-sparing surgery) میگویند. ممکن است از پیوند بافت یا ایمپلنت برای جایگزینی بافت برداشته شده استفاده شود. این ممکن است با پرتو درمانی دنبال شود.
گاهی اوقات نمیتوان از قطع عضو جلوگیری کرد. شاید این تنها راه برای از بین بردن تمام سرطان باشد. در موارد دیگر، اعصاب کلیدی، ماهیچهها، استخوان و عروق خونی باید همراه با سرطان برداشته شوند. اگر برداشتن این بافت به معنای ترک عضوی است که به خوبی کار نمیکند یا منجر به درد مزمن میشود، ممکن است قطع عضو بهترین گزینه باشد.
جراحی اگر سارکوم گسترش یافته باشد
اگر سارکوم به نقاط دور (مانند ریهها یا سایر اندامها) گسترش یافته باشد، در صورت امکان تمام سرطان برداشته میشود.
این شامل تومور اصلی به علاوه مناطق گسترش است. اگر حذف تمام سارکوم ممکن نباشد، ممکن است اصلاً جراحی انجام نشود.
اغلب اوقات، جراحی به تنهایی نمیتواند سارکوم را پس از گسترش درمان کند اما اگر فقط به چند نقطه در ریه گسترش یافته باشد، گاهی اوقات میتوان تومورهای متاستاتیک را برداشت. این میتواند بیماران را درمان کند یا حداقل منجر به بقای طولانی مدت شود.
تشریح غدد لنفاوی (Lymph node dissection)
اگر غدد لنفاوی نزدیک تومور بزرگ شوند، ممکن است سرطان در آنها باشد. در طول جراحی، برخی از گرههای متورم ممکن است به آزمایشگاه فرستاده شوند و از نظر سرطان بررسی شوند. اگر سرطان پیدا شود، غدد لنفاوی ناحیه برداشته خواهند شد. ممکن است پس از جراحی از پرتو درمانی در آن ناحیه استفاده شود.
درمانهای مورد استفاده با جراحی
گاهی ممکن است قبل از جراحی شیمی درمانی (chemo)، پرتو درمانی یا هر دو انجام شود. به این درمان نئوادجوانت (neoadjuvant treatment) میگویند. میتوان از آن برای کوچک کردن تومور استفاده کرد تا بتوان آن را به طور کامل برداشت. همچنین میتوان قبل از عمل جراحی برای درمان سارکومهای با درجه بالا، زمانی که خطر گسترش سرطان وجود دارد، شیمی درمانی یا پرتو درمانی تجویز کرد.
همچنین ممکن است پس از جراحی از شیمی درمانی و یا پرتو درمانی استفاده شود. این درمان کمکی (adjuvant treatment) نامیده میشود. هدف از بین بردن سلولهای سرطانی است که ممکن است در بدن باقی بماند تا خطر بازگشت سرطان کاهش یابد.
پرتو درمانی (Radiation Therapy) برای سارکومهای بافت نرم
پرتو درمانی از پرتوهای پر انرژی (مانند اشعه ایکس) یا ذرات برای از بین بردن سلولهای سرطانی استفاده میکند. این بخش کلیدی از درمان سارکوم بافت نرم است.
- بیشتر اوقات پس از جراحی پرتو داده میشود. این درمان کمکی نامیده میشود. این کار برای از بین بردن سلولهای سرطانی که ممکن است پس از جراحی باقی بماند، انجام میشود. تابش میتواند بر بهبود زخم تأثیر بگذارد، بنابراین ممکن است تا یک ماه یا بیشتر پس از جراحی شروع نشود.
- همچنین ممکن است قبل از جراحی برای کوچک کردن تومور و آسانتر کردن برداشتن آن از پرتو درمانی استفاده شود. به این درمان نئوادجوانت میگویند.
پرتو درمانی میتواند روش درمانی اصلی سارکوم در فردی باشد که به اندازه کافی سالم نیست تا جراحی کند. از پرتو درمانی نیز میتوان برای کمک به کاهش علائم سارکوم در صورت گسترش آن استفاده کرد. این درمان تسکینی (palliative treatment) نامیده میشود.
انواع پرتو درمانی
- پرتوهای خارجی (External beam radiation): این نوع پرتو درمانی است که اغلب برای درمان سارکوم استفاده میشود. درمانها اغلب به صورت روزانه، 5 روز در هفته، معمولا برای چند هفته انجام میشود. در بیشتر موارد، تکنیکی به نام پرتو درمانی تعدیل شده شدت (IMRT یا intensity modulated radiation therapy) استفاده میشود. این کار تابش را روی سرطان متمرکز میکند و آسیب به بافت سالم را کاهش میدهد.

- تشعشعات پرتو پروتون (Proton beam radiation): برای درمان سرطان به جای پرتوهای اشعه ایکس از جریانهای پروتون استفاده میشود. اگرچه این روش در تئوری مزایایی نسبت به IMRT دارد اما ثابت نشده است که درمان بهتری برای سارکوم بافت نرم است. درمان پرتو پروتون به طور گسترده ای در دسترس نیست.
- پرتو درمانی حین عمل (IORT یا Intraoperative radiation therapy): در این نوع درمان، پس از برداشتن تومور اما قبل از بسته شدن زخم، یک دوز بزرگ پرتو در اتاق عمل داده میشود. پرتو دادن از این طریق به این معنی است که برای رسیدن به ناحیه ای که نیاز به درمان دارد، نیازی به عبور از بافت سالم نیست. همچنین این امکان را فراهم میکند که مناطق سالم نزدیک به راحتی در برابر تشعشعات محافظت شوند. اغلب، IORT تنها بخشی از پرتو درمانی است و بیمار پس از جراحی، نوع دیگری از اشعه را دریافت میکند.
- براکی تراپی (Brachytherapy): گاهی اوقات پرتو درمانی داخلی (internal radiation therapy) نامیده میشود، درمانی است که گلولههای کوچک (یا دانههای) مواد رادیو اکتیو را در داخل یا نزدیک سرطان قرار میدهد. برای سارکوم بافت نرم، این گلولهها در کاتترها (لولههای بسیار نازک و نرم) که در حین جراحی قرار داده شده اند، قرار میگیرند. براکی تراپی ممکن است تنها شکل پرتو درمانی مورد استفاده باشد یا میتواند با پرتوهای خارجی ترکیب شود.
عوارض جانبی پرتو درمانی
عوارض جانبی پرتو درمانی به قسمتی از بدن که تحت درمان قرار گرفته و دوز تجویز شده بستگی دارد. عوارض جانبی رایج عبارتند از:
- تغییرات پوستی در جایی که تشعشع از پوست عبور میکند که میتواند از قرمزی تا تاول زدن و پوسته پوسته شدن متغیر باشد.
- خستگی
- تهوع و استفراغ (شایع تر با تشعشع به شکم)
- اسهال (شایع ترین با تشعشع به لگن و شکم)
- درد هنگام بلع (ناشی از تشعشعات به سر، گردن یا قفسه سینه)
- آسیب ریه که منجر به مشکلات تنفسی میشود (ناشی از تابش به قفسه سینه)
- ضعف استخوان که میتواند منجر به بروز شکستگی در سالها بعد شود.
تابش نواحی بزرگ بازو یا پا میتواند باعث تورم، درد و ضعف در آن اندام شود.
عوارض جانبی پرتو درمانی به مغز برای سارکوم متاستاتیک شامل ریزش مو (در این مورد میتواند دائمی باشد)، سردرد و مشکلات فکری است.
اگر قبل از جراحی داده شود، اشعه ممکن است باعث ایجاد مشکلاتی در بهبود زخم شود. اگر بعد از جراحی داده شود، میتواند باعث سفتی و تورم طولانی مدت شود که میتواند بر عملکرد اندام تأثیر بگذارد.
بسیاری از عوارض جانبی پس از اتمام تابش بهبود مییابند یا حتی از بین میروند. برخی از آنها، مانند ضعف استخوان و آسیب ریه، میتوانند دائمی باشند.
شیمی پرتویی (Chemoradiation)
پس از جراحی، برخی از سارکومهای درجه بالا ممکن است با پرتو درمانی و شیمی درمانی همزمان درمان شوند. به این عمل شیمی پرتویی (Chemoradiation) میگویند.
در مواردی که سارکوم نمیتواند برداشته شود یا برداشتن آن آسیب بزرگی ایجاد میکند، ممکن است قبل از جراحی نیز انجام شود. گاهی اوقات، شیمی درمانی میتواند تومور را به اندازه کافی کوچک کند تا از این اتفاقات جلوگیری کند تا بتوان آن را حذف کرد.
شیمی پرتویی میتواند عوارض جانبی عمده ای ایجاد کند. همه متخصصان در مورد ارزش آن در درمان سارکوم توافق ندارند. به نظر میرسد پرتو درمانی به تنهایی پس از عمل جراحی مانند شیمی درمانی موثر است. هنوز برای برخی موارد، این ممکن است یک گزینه درمانی برای بررسی باشد.
شیمی درمانی (Chemotherapy) برای سارکوم بافت نرم
شیمی درمانی (chemo) استفاده از داروهایی است که در ورید یا از طریق دهان برای درمان سرطان مصرف میشود. این داروها وارد جریان خون میشوند و به تمام نواحی بدن میرسند و این امر درمان را برای سرطانی که به سایر اندامها گسترش یافته (متاستاز داده) مفید میکند.
بسته به نوع و مرحله سارکوم، شیمی درمانی ممکن است به عنوان درمان اصلی یا کمکی (افزودنی) به جراحی انجام شود. انواع مختلف سارکوم بهتر از سایرین به شیمی درمانی و همچنین به انواع مختلف شیمی درمانی پاسخ میدهند. شیمی درمانی برای سارکوم بافت نرم معمولاً از ترکیبی از چندین داروی ضد سرطان استفاده میکند.
داروهای شیمیایی مورد استفاده برای سارکوم
رایج ترین داروهای مورد استفاده، ایفوسفامید (Ifex®) و دوکسوروبیسین (Adriamycin®) هستند. هنگام استفاده از ایفوسفامید، داروی مسنا (Mesna) نیز تجویز میشود. مسنا داروی شیمی درمانی نیست. این دارو برای محافظت از مثانه در برابر اثرات سمی ایفوسفامید استفاده میشود.
سایر داروهای شیمی درمانی نیز ممکن است مورد استفاده قرار گیرند، از جمله داکاربازین (DTIC)، اپی روبیسین (epirubicin)، تموزولوماید (Temodar®)، دوستاکسل (Taxotere®)، جمسیتابین (Gemzar®)، وینورلبین (Navelbine®)، ترابکتدین (Yondelis®) و eribulin ( Halaven®).
هنگامی که چندین دارو با هم استفاده میشوند، نام کوتاه شده ای به ترکیب داده میشود مانند: MAID (مسنا، آدریامایسین [دوکسوروبیسین]، ایفوسفامید و داکاربازین) یا AIM (آدریامایسین [دوکسوروبیسین]، ایفوسفامید و مسنا).
پرفیوژن ایزوله اندام (Isolated limb perfusion یا ILP)

ILP روشی متفاوت برای دادن شیمی درمانی است. گردش اندام (بازو یا پا) با تومور در آن از گردش خون بقیه بدن جدا میشود. سپس شیمی درمانی فقط به آن اندام داده میشود. گاهی اوقات برای کمک به عملکرد بهتر شیمی درمانی، خون کمی گرم میشود (به این حالت هایپرترمی یا hyperthermia میگویند).
ILP ممکن است برای درمان تومورهایی که قابل برداشتن نیستند یا برای درمان تومورهای درجه بالا قبل از جراحی استفاده شود. این میتواند به کوچک کردن تومورها کمک کند اما مشخص نیست که به بیماران کمک میکند تا بیشتر از شیمی درمانی استاندارد زندگی کنند. ILP فقط باید در مراکزی انجام شود که تجربه زیادی در انجام شیمی درمانی از این طریق دارند.
عوارض جانبی شیمی درمانی
داروهای شیمی درمانی سلولهای سرطانی را از بین میبرند اما به برخی از سلولهای طبیعی نیز آسیب میرسانند. این امر باعث عوارض جانبی میشود. عوارض جانبی به نوع دارو، مقدار مصرف و طول دوره درمان بستگی دارد. عوارض جانبی رایج شیمی درمانی عبارتند از:
- تهوع و استفراغ
- از دست دادن اشتها
- ریزش مو
- زخمهای دهانی
- خستگی
- شمارش خون پایین
از آن جایی که شیمی درمانی میتواند به سلولهای تولید کننده خون مغز استخوان آسیب برساند، بیماران ممکن است تعداد سلولهای خونی پایینی داشته باشند. این میتواند منجر به:
- افزایش احتمال عفونت (ناشی از گلبولهای سفید بسیار کم)
- مشکلات خونریزی یا کبودی (ناشی از تعداد بسیار کم پلاکتهای خون)
- خستگی و ضعف (ناشی از گلبولهای قرمز بسیار کم)
اکثر عوارض جانبی پس از قطع دوره درمان به مرور زمان از بین میروند. به عنوان مثال، موها پس از پایان دوره درمان دوباره رشد خواهند کرد اما ممکن است متفاوت به نظر برسند. درمانهایی برای بسیاری از عوارض جانبی کوتاه مدت شیمی درمانی وجود دارد. به عنوان مثال، میتوان داروهایی تجویز کرد که از تهوع و استفراغ جلوگیری کرده یا آنها را کاهش میدهند.
برخی از عوارض جانبی شیمی درمانی ممکن است طولانی مدت یا حتی دائمی باشند. به عنوان مثال، دوکسوروبیسین در صورت تجویز بیش از حد میتواند قلب را ضعیف کند. اگر میخواهید این دارو را دریافت کنید، ممکن است پزشک قبل از شروع این دارو، عملکرد قلب شما را با مطالعات ویژه بررسی کند. پزشک همچنین عملکرد قلب شما را در طول روند درمان بررسی خواهد کرد.
برخی از داروهای شیمی درمانی باعث آسیب عصبی (به نام نوروپاتی یا neuropathy) میشوند که منجر به بی حسی، سوزن سوزن شدن یا حتی درد در دستها و پاها میشود.
شیمی درمانی همچنین ممکن است به طور دائمی به تخمدانها یا بیضهها آسیب برساند و باعث ناباروری (عدم بچه دار شدن) شود.
درمان دارویی هدفمند (Targeted Drug Therapy) برای سارکوم بافت نرم
داروهای درمان هدفمند به بخشهایی از سلولهای سرطانی حمله میکنند که آنها را از سلولهای سالم و طبیعی متفاوت میکند. این داروها با داروهای استاندارد شیمی درمانی متفاوت عمل میکنند و اغلب انواع مختلفی از عوارض جانبی دارند. هر نوع درمان هدفمند به طور متفاوتی عمل میکند اما همه آنها بر نحوه رشد، تقسیم، ترمیم یا تعامل سلول سرطانی با سلولهای دیگر تأثیر میگذارند.
همان طور که پزشکان درباره بیولوژی سلولهای سارکوم بیشتر میآموزند، درمان هدفمند در حال تبدیل شدن به یک گزینه درمانی مهم برای برخی از سارکومهای بافت نرم است.
Pazopanib (Votrient)
پازوپانیب چندین آنزیم سلولی به نام تیروزین کیناز (tyrosine kinases) را که برای رشد و بقای سلول مهم هستند، مسدود میکند. این دارو ممکن است برای درمان برخی از سارکومهای پیشرفته بافت نرم که به شیمی درمانی پاسخ نداده اند، استفاده شود.
این دارو میتواند به کند کردن رشد تومور و کاهش عوارض جانبی در بیماران مبتلا به سارکوم که با جراحی قابل برداشتن نیستند، کمک کند. با این حال، تا کنون مشخص نیست که این دارو به افراد کمک میکند تا عمر طولانی تری داشته باشند.
پازوپانیب به شکل قرص، یک بار در روز مصرف میشود.
اثرات جانبی
عوارض جانبی رایج عبارتند از فشار خون بالا، خستگی، حالت تهوع، اسهال، سردرد، تغییر رنگ مو، کاهش تعداد سلولهای خونی و مشکلات کبدی. در برخی از بیماران این دارو باعث نتایج غیر طبیعی در آزمایشات عملکرد کبد میشود اما به ندرت منجر به آسیب شدید کبدی میشود که میتواند زندگی را تهدید کند.
خونریزی، لخته شدن و مشکلات ترمیم زخم نادر است اما ممکن است رخ دهد. این دارو همچنین به ندرت باعث ایجاد مشکل در ریتم قلب یا حتی حمله قلبی میشود.
اگر پازوپانیب مصرف میکنید، پزشک قلب شما را با EKG کنترل میکند و آزمایش خون را برای بررسی مشکلات کبدی یا سایر تغییرات انجام میدهد.
Tazemetostat (Tazverik)
Tazemetostat با هدف قرار دادن EZH2، پروتئینی به نام متیل ترانسفراز (methyltransferase) که به طور معمول به رشد برخی از سلولهای سرطانی کمک میکند، عمل میکند. این دارو را میتوان برای درمان سارکومهای اپیتلیوئیدی که نمیتوان آنها را به طور کامل با جراحی از بین برد، استفاده کرد. این دارو میتواند رشد برخی از این سرطانها را کوچک یا کند کند، اگرچه هنوز مشخص نیست که آیا میتواند به افراد کمک کند تا عمر طولانیتری داشته باشند یا خیر.
این دارو به صورت قرص معمولاً دو بار در روز مصرف میشود.
اثرات جانبی
شایع ترین عوارض جانبی این دارو شامل درد، خستگی، حالت تهوع، استفراغ، کاهش اشتها و یبوست است. تازمتوستات همچنین میتواند خطر ابتلا به برخی از انواع سرطانهای خون، از جمله لوسمیها و لنفومها را افزایش دهد.
سایر داروهای هدفمند
بسیاری از داروهای هدفمند دیگر نیز ممکن است در درمان انواع خاصی از سارکوم بافت نرم مفید باشند. نمونههایی از این داروها عبارتند از:
- Regorafenib (Stivarga)
- Sorafenib (Nexavar)
- Sunitinib (Sutent)
- Larotrectinib (Vitrakvi) (برای تومورهایی با تغییر ژن NTRK)
- Entrectinib (Rozlytrek) (برای تومورهای دارای تغییر ژن NTRK)
- نانوذرات متصل به آلبومین سیرولیموس (همچنین به عنوان nab-sirolimus یا Fyarro شناخته میشود) (برای PEComas بدخیم پیشرفته)
ایمونوتراپی (Immunotherapy) برای سارکوم بافت نرم
ایمونوتراپی استفاده از داروها برای کمک به سیستم ایمنی بدن خود فرد است که سلولهای سرطانی را به طور موثرتری شناسایی و آنها را از بین ببرد.
مهار کنندههای ایست بازرسی ایمنی
بخش مهمی از سیستم ایمنی، توانایی آن در جلوگیری از حمله به سلولهای طبیعی بدن است. برای انجام این کار، از «نقاط بازرسی یا checkpoints » استفاده میکند – پروتئینهای روی سلولهای ایمنی یا سلولهای دیگری که برای شروع پاسخ ایمنی باید روشن یا خاموش شوند. سلولهای سرطانی گاهی اوقات از این نقاط بازرسی برای جلوگیری از حمله سیستم ایمنی استفاده میکنند اما داروهایی که این نقاط بازرسی را هدف قرار میدهند، معروف به مهار کنندههای ایست بازرسی، میتوانند برای درمان برخی از افراد مبتلا به سارکوم بافت نرم استفاده شوند.
مهار کنندههای PD-1 و PD-L1
PD-1 یک پروتئین نقطه بازرسی بر روی سلولهای ایمنی به نام سلولهای T است. به طور معمول به عنوان یک نوع “سوئیچ خاموش” عمل میکند که به جلوگیری از حمله سلولهای T به سایر سلولهای بدن کمک میکند. وقتی به PD-L1 – پروتئینی روی برخی سلولهای طبیعی (و سرطانی) – متصل میشود، این کار را انجام میدهد. وقتی PD-1 به PD-L1 متصل میشود، اساساً به سلول T میگوید که سلول دیگر را تنها بگذارد. برخی از سلولهای سرطانی دارای مقادیر زیادی PD-L1 هستند که به آنها کمک میکند از حمله سلولهای ایمنی جلوگیری کنند.
Atezolizumab (Tecentriq) پروتئین PD-L1 را هدف قرار میدهد. این دارو با مسدود کردن PD-L1، پاسخ ایمنی در برابر سلولهای سرطانی را تقویت میکند. این میتواند برخی از تومورها را کوچک کند یا رشد آنها را کند کند.
آتزولیزوماب را میتوان در افراد مبتلا به سارکوم قسمت نرم آلوئولی که با جراحی برداشته نمیشود یا به سایر قسمتهای بدن گسترش یافته (متاستاز داده) استفاده کرد.
این دارو به صورت انفوزیون داخل وریدی (IV) معمولاً هر 2، 3 یا 4 هفته تجویز میشود.
پمبرولیزوماب (Keytruda) پروتئین PD-1 را هدف قرار میدهد که همچنین میتواند به سیستم ایمنی کمک کند تا به سلولهای سرطانی حمله کند. در حالی که این دارو توسط FDA به طور خاص برای درمان سارکوم بافت نرم تایید نشده اما برای درمان سایر سرطانها تایید شده است. برخی از مطالعات اولیه نشان داده اند که این دارو میتواند در برابر انواع خاصی از سارکومهای بافت نرم پیشرفته مفید باشد، بنابراین ممکن است در برخی شرایط گزینه مناسبی باشد. همچنین اگر مشخص شود سلولهای سارکوم دارای تغییرات خاصی در ژن یا پروتئین هستند، ممکن است گزینه خوبی باشد.
این دارو به صورت انفوزیون داخل وریدی (IV) معمولاً هر 3 یا 6 هفته تجویز میشود.
عوارض جانبی احتمالی مهار کنندههای ایست بازرسی
عوارض جانبی این نوع داروها میتواند شامل خستگی، سرفه، حالت تهوع، خارش، زوائد پوستی، از دست دادن اشتها، یبوست، درد مفاصل و اسهال باشد.
سایر عوارض جانبی جدی تر کمتر رخ میدهد:
واکنشهای انفوزیونی یا تزریقی (Infusion reactions): برخی از افراد ممکن است در حین مصرف یکی از این داروها، واکنش انفوزیونی داشته باشند. این مانند یک واکنش آلرژیک است و میتواند شامل تب، لرز، برافروختگی صورت، زوائد پوستی، خارش پوست، احساس سرگیجه، خس خس سینه و مشکل در تنفس باشد. مهم است که در صورت داشتن هر یک از این علائم در حین مصرف یکی از این داروها، فوراً به پزشک یا پرستار خود اطلاع دهید.
واکنشهای خود ایمنی (Autoimmune reactions): این داروها اساساً با حذف یکی از محافظهای سیستم ایمنی بدن عمل میکنند. گاهی اوقات سیستم ایمنی شروع به حمله به سایر قسمتهای بدن میکند که میتواند باعث مشکلات جدی یا حتی تهدید کننده زندگی در ریهها، رودهها، کبد، غدد هورمون ساز، کلیهها یا سایر اندامها شود.
بسیار مهم است که هر گونه عوارض جانبی جدید را در اسرع وقت به تیم مراقبتهای بهداشتی خود گزارش دهید. در صورت بروز عوارض جانبی جدی، ممکن است لازم باشد روند درمان متوقف شود و ممکن است دوزهای بالایی از کورتیکواستروئیدها (corticosteroids) برای سرکوب سیستم ایمنی خود دریافت کنید.
درمان سارکوم بافت نرم به تفکیک مرحله
بهترین شانس برای درمان سارکوم بافت نرم، برداشتن آن با جراحی است، بنابراین جراحی بخشی از درمان همه سارکومهای بافت نرم در صورت امکان است. این مهم است که جراح و سایر پزشکان در درمان سارکوم تجربه داشته باشند. درمان این تومورها سخت است و به تجربه و تخصص نیاز دارد. مطالعات نشان داده اند که افراد مبتلا به سارکوم زمانی که در مراکز تخصصی سرطان که تجربه درمان سارکوم را دارند، درمان میشوند، نتایج بهتری دارند.
درمان به طور کلی برای اکثر انواع سارکوم بافت نرم، به ویژه برای سارکومهای مرحله اولیه مشابه است اما در سالهای اخیر، از آن جایی که پزشکان بیشتر در مورد تفاوتهای بین انواع آنها یاد گرفته اند، درمان هدفمند جدیدتر و داروهای ایمونوتراپی به گزینههای درمانی مهمی برای برخی از انواع سارکومهای بافت نرم پیشرفته تبدیل شدهاند.
سارکومهای بافت نرم مرحله I
سارکومهای بافت نرم مرحله I تومورهای درجه پایین در هر اندازه ای هستند. تومورهای کوچک (کمتر از 5 سانتی متر یا حدود 2 اینچ) در بازوها یا پاها ممکن است تنها با جراحی درمان شوند.
هدف از جراحی برداشتن تومور با مقداری از بافت طبیعی اطراف آن است. اگر سلولهای سرطانی در لبههای بافت برداشته شده یا نزدیک آنها یافت شوند (که حاشیههای مثبت یا نزدیک نامیده میشود)، میتواند به این معنی باشد که برخی از سرطانها باقی مانده است. اغلب بهترین گزینه برای حاشیههای مثبت یا نزدیک، جراحی بیشتر است. گزینه دیگر درمان با پرتو درمانی پس از جراحی است. این امر احتمال عود سرطان را کاهش میدهد.
اگر تومور در اندام نباشد (مثلاً در سر، گردن یا شکم)، بیرون آوردن کل تومور و بافت طبیعی کافی اطراف آن دشوارتر است. برای این تومورها، پرتو درمانی با شیمی درمانی (شیمی پرتویی) یا بدون آن ممکن است قبل از جراحی داده شود. این ممکن است به اندازه کافی تومور را کوچک کند تا با جراحی آن را به طور کامل حذف کند. اگر قبل از جراحی از اشعه استفاده نشود، ممکن است پس از جراحی برای کمک به کاهش احتمال عود تومور داده شود.
سارکومهای بافت نرم مرحله II و III
اکثر سارکومهای مرحله II و III تومورهای با درجه بالا هستند. آنها تمایل به رشد و گسترش سریع دارند. برخی از تومورهای مرحله III قبلاً به غدد لنفاوی مجاور گسترش یافته اند. حتی زمانی که این سارکومها هنوز به غدد لنفاوی گسترش نیافته اند، خطر گسترش (به غدد لنفاوی یا سایر قسمتهای بدن) بسیار زیاد است. این تومورها همچنین تمایل دارند پس از برداشتن در همان ناحیه دوباره رشد کنند. (به این عود موضعی یا local recurrence میگویند.)
برای تمام سارکومهای مرحله II و III، برداشتن تومور با جراحی روش درمانی اصلی است. اگر غدد لنفاوی ممکن است حاوی سرطان باشند نیز برداشته خواهند شد. ممکن است پس از جراحی پرتو درمانی داده شود.
اگر تومور بزرگ باشد یا در جایی باشد که جراحی را دشوار کند اما در غدد لنفاوی نباشد، ممکن است بیمار قبل از جراحی با شیمی درمانی، پرتو درمانی یا هر دو درمان شود. (برای تومورهای بزرگ در بازوها یا پاها، شیمی درمانی با پرفیوژن ایزوله اندام نیز یک گزینه است.) هدف از درمان، کوچک کردن تومور است و برداشتن آن آسان تر است. ممکن است پس از جراحی شیمی درمانی، پرتو درمانی یا هر دو نیز داده شود. این درمانها احتمال بازگشت تومور را در همان جایی که شروع شده یا نزدیک آن، کاهش میدهد.
تومورهای کوچکتر ممکن است ابتدا با جراحی و سپس پرتو درمانی برای کمک به کاهش خطر بازگشت تومور درمان شوند.
در موارد نادر، ممکن است برای برداشتن کل تومور به قطع قسمتی یا تمام اندام نیاز باشد، اگرچه این کار در حال حاضر بسیار کمتر از گذشته انجام میشود.
پرتو درمانی با شیمی درمانی یا بدون آن را میتوان به تنهایی زمانی که مکان یا اندازه تومور یا سلامت کلی بیمار جراحی را غیر ممکن میکند، استفاده کرد.
سارکوم بافت نرم مرحله IV
سارکوم زمانی مرحله IV در نظر گرفته میشود که به نقاط دور دست بدن گسترش یافته باشد. سارکومهای مرحله IV به ندرت قابل درمان هستند اما در صورتی که تومور اصلی (اولیه) و تمام نواحی گسترش سرطان (متاستازها) را بتوان با جراحی از بین برد، برخی از بیماران ممکن است درمان شوند.
بهترین میزان موفقیت زمانی است که فقط به ریهها گسترش یافته باشد. در این مورد، تومورهای اصلی مانند مراحل II یا III درمان میشوند و در صورت امکان متاستازها به طور کامل حذف میشوند. این هنوز حوزه ای است که پزشکان در مورد اینکه بهترین درمان چیست و چه بیمارانی بیشتر سود میبرند، اختلاف نظر دارند.
برای افرادی که تومور اولیه و تمام متاستازها را نمیتوان به طور کامل با جراحی برداشت، پرتو درمانی و یا شیمی درمانی اغلب استفاده میشود. داروهای شیمی درمانی دوکسوروبیسین و ایفوسفامید اغلب اولین انتخاب هستند – یا همراه با سایر داروها. در صورتی که اولین ترکیب موثر نباشد یا اثر خود را متوقف کند، ممکن است جمسیتابین و دوستاکسل تجویز شود.
افراد مبتلا به آنژیوسارکوم ممکن است از درمان با پاکلیتاکسل یا دوستاکسل با وینورلبین سود ببرند.
برای برخی از انواع سارکوم بافت نرم، درمان با داروهای هدفمند جدیدتر یا ایمونوتراپی نیز ممکن است یک گزینه باشد.
سارکومهای عود کننده (Recurrent sarcomas)
سرطان زمانی که پس از درمان باز میگردد، عود کننده (recurrent) نامیده میشود. عود میتواند موضعی (در همان جایی که شروع شده است یا نزدیک آن) یا دور (به سایر اندامها یا بافتها مانند ریهها یا مغز) گسترش یابد.
اگر سارکوم در همان ناحیه ای که شروع شده بازگردد، ممکن است با جراحی درمان شود. پرتو درمانی ممکن است پس از جراحی انجام شود، به خصوص اگر پرتو درمانی بخشی از درمان تومور اصلی نباشد. اگر قبلاً از پرتو درمانی خارجی استفاده میشد، براکی تراپی ممکن است همچنان یک گزینه باشد.
اگر سارکوم در قسمتی دورتر از بدن بازگردد، شیمی درمانی، درمان هدفمند یا داروهای ایمونوتراپی ممکن است گزینههای خوبی باشند. اگر سارکوم فقط به ریهها گسترش یافته باشد، ممکن است بتوان تمام نواحی گسترش را با جراحی برداشت. از پرتو درمانی اغلب برای درمان سارکومهایی که به مغز سرایت میکنند و همچنین عودهایی که باعث علائمی مانند درد میشوند، استفاده میشود.
چه چیز جدیدی در تحقیق سارکوم بافت نرم وجود دارد؟
تحقیقات در زمینه سارکوم بافت نرم در حال انجام است. از آن جایی که سارکومهای بافت نرم نادر هستند و انواع مختلفی دارند، مطالعه آنها به خوبی دشوار بوده است. با این حال، دانشمندان در حال یادگیری بیشتر در مورد علل و تفاوتهای ژنتیکی در انواع سارکوم بوده و به دنبال راههایی برای بهبود درمان هستند.
تحقیقات پایه
دانشمندان در درک اینکه چگونه تغییرات ژنی خاص در سلولهای بافت نرم باعث ایجاد سارکوم میشود، پیشرفت کرده اند. این اطلاعات در حال حاضر در آزمایشهای جدید برای تشخیص و طبقه بندی سارکوم استفاده میشود. این مهم است زیرا دانستن نوع دقیق سارکوم به پزشکان کمک میکند تا درمان متناسب با هر فرد را انتخاب کنند. امید است که این اطلاعات همچنین منجر به یافتن راههای جدیدی برای درمان این سرطانها، بر اساس تفاوتهای خاص بین سلولهای بافت نرم طبیعی و سرطانی شود.
طبقه بندی
طبقه بندی اکثر سرطانها، از جمله سارکومها، بیشتر بر اساس نوع ظاهر آنها در زیر میکروسکوپ است. تحقیقات اخیر نشان داده است که چندین نوع مختلف سارکوم بافت نرم میتوانند در زیر میکروسکوپ بسیار شبیه به هم به نظر برسند.
با استفاده از آزمایشهای جدید، محققان دریافتهاند که بیشتر سرطانهایی که قبلا هیستیوسیتوم فیبری بدخیم (MFH) نامیده میشدند، در واقع اشکال با درجه بالایی از لیپوسارکوم، رابدومیوسارکوم، لیومیوسارکوم، سارکومهای دیگر و حتی کارسینوم یا لنفوم هستند. آزمایشهایی برای طبقه بندی واضح بسیاری از انواع سارکوم بافت نرم، کلید دیگری برای تصمیم گیری در مورد بهترین درمان برای هر فرد است.
درمان
محققان به دنبال راههای جدید و بهتری برای ترکیب درمانها، بهعنوان مثال، استفاده از جراحی، پرتو درمانی و شیمیدرمانی با هم و همچنین راههای جدید برای درمان سارکوم بافت نرم هستند.
پرتو درمانی
پزشکان به دنبال بهترین راه برای استفاده از پرتو درمانی هستند. مطالعات استفاده از پرتو را قبل و بعد از جراحی مقایسه میکنند تا بفهمند کدام یک تأثیر بیشتری بر بهبود زخم و عوارض جانبی طولانی مدت دارد. آنها همچنین در تلاش برای یافتن راههای بهتر و ایمنتر برای استفاده از این روش درمانی، انواع، دوزها و برنامههای پرتو درمانیهای مختلف را بررسی میکنند. همچنین تحقیقاتی در حال انجام است تا مشخص شود چه زمانی پس از جراحی به پرتودهی نیاز است و چه زمانی نیاز نیست.
شیمی درمانی
تحقیقات فعال در شیمی درمانی برای سارکوم بافت نرم شامل مطالعات داروهای جدید و روشهای جدید برای دادن داروهای موجود است.
درمان هدفمند
تحقیقات فعال زیادی در مورد استفاده از داروهای هدفمند وجود دارد. این داروها به طور خاص مواد درون یا روی سلولهای سرطانی را که باعث رشد سرطانها میشوند را مسدود میکنند. درمانهای هدفمند برای بسیاری از انواع سرطان استفاده میشود و پزشکان در تلاشند تا دریابند که آیا این درمانها در برابر سارکوم نیز مفید هستند یا خیر.
داروهای ضد رگ زایی
داروهایی که تشکیل رگهای خونی جدید را مسدود میکنند ممکن است به کشتن سارکومها با جلوگیری از تغذیه آنها توسط رگهای خونی کمک کنند. این داروها در بسیاری از مطالعات در حال آزمایش هستند.
سایر درمانها
بسیاری از درمانهای دیگر در حال آزمایش اند و فقط در آزمایشات بالینی در دسترس هستند. به عنوان مثال میتوان به درمان با واکسن و درمان با سلولهای T برای افراد مبتلا به سارکوم بافت نرم پیشرفته اشاره کرد. استفاده از گرما (هیپرترمی یا hyperthermia) و سرما (کرایوسرجری یا cryosurgery) برای از بین بردن تومورها نیز در حال بررسی است. بیشتر این مطالعات در مراحل اولیه هستند و مدتی طول میکشد تا پزشکان مطمئن شوند که به اندازه کافی خوب عمل میکنند تا بخشی از روند درمان منظم سارکوم بافت نرم باشند.
همچنین بخوانید:
- سرطان تیروئید (Thyroid Cancer) چیست؟ علائم، تشخیص و درمان
- تومورهای استرومال دستگاه گوارش (Gastrointestinal Stromal Tumors) چیست؟ علائم، تشخیص و درمان
- تومور کارسینوئید دستگاه گوارش چیست؟ علائم، پیشگیری و درمان
- مزوتلیومای بدخیم چیست؟ تعریف، علائم، پیشگیری و درمان
مترجم: فاطمه فریادرس





سلام وقت بخیر
برای فهمیدن انواع سرطان سارکوم ک اینجا بیان شده فقط سونوگرافی کافیه؟؟
سلام
خیر، سونوگرافی بهتنهایی کافی نیست.
سونو فقط میتواند توده را نشان دهد؛ برای تشخیص نوع سارکوم نیاز به MRI/CT و تشخیص قطعی با بیوپسی (نمونهبرداری) است.
سلام
وقتتون بخیر
من دو تا توده روی بازو و پشت کتفم ۶ماه قبل زده بود ک با جراحی برداشتم نمونه برداری شد و گفتن خوش خیم هست
الن دوباره روی بازو ی توده دیگه پیدا شده میشه راهنمایی کنید باید چیکار کنم
آزمایش یا دوباره جراحی؟
اگر توده جدید دوباره ایجاد شده، اول سونوگرافی بافت نرم انجام دهید.
اگر سونو مشکوک یا در حال رشد بود → نمونهبرداری (FNA یا بیوپسی).
جراحی فقط زمانی لازم است که دردناک، بزرگشونده یا مشکوک باشد.
اغلب این موارد لیپوما یا توده خوشخیم عودکننده هستند، اما بررسی تصویربرداری اولویت دارد.